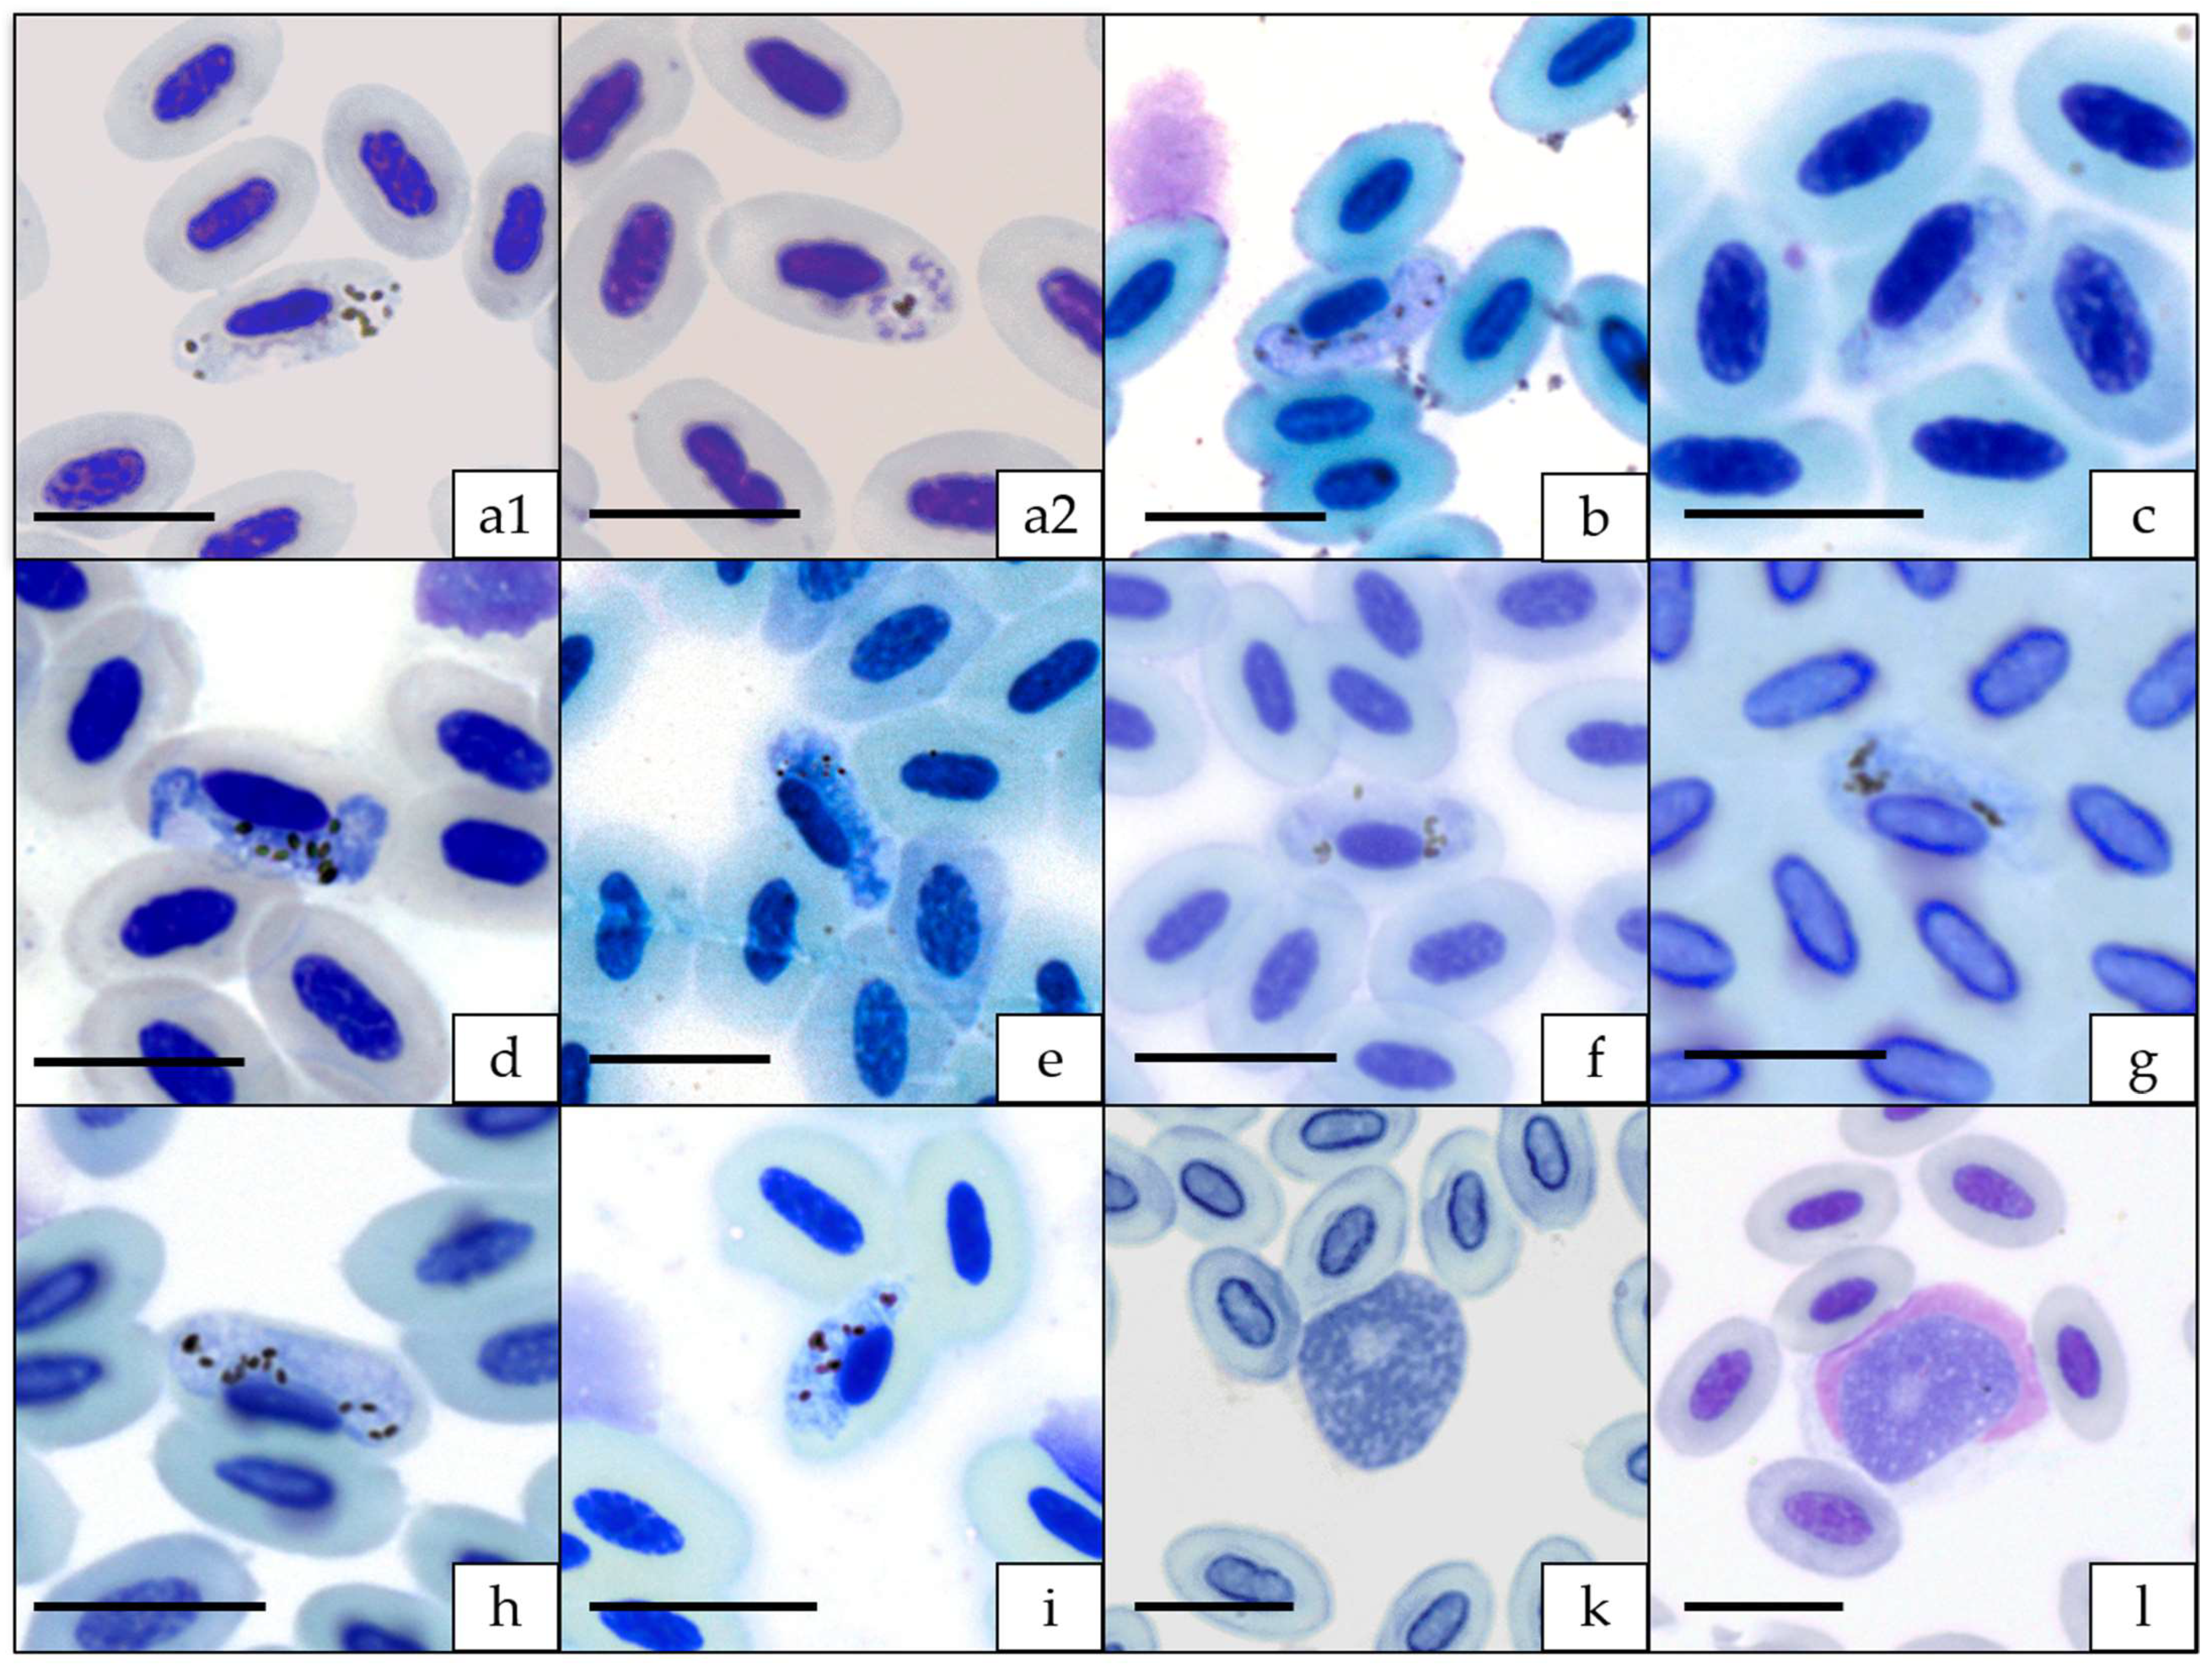
Diversity 14 00888 g001

Blood Parasites of Vangas and Other Corvoidea on Madagascar
Abstract
1. Introduction
2. Materials and Methods
3. Results
3.1. Microscopic, Molecular, and Phylogenetic Analyses of Haemosporidian Parasites
3.2. Microscopic, Molecular and Phylogenetic Analyses of Trypanosomes
3.3. Microscopic, Molecular, and Phylogenetic Analyses of Microfilariae
4. Discussion
4.1. Haemosporida
4.2. Trypanosoma
4.3. Microfilariae
5. Conclusions
Supplementary Materials
Author Contributions
Funding
Institutional Review Board Statement
Informed Consent Statement
Data Availability Statement
Acknowledgments
Conflicts of Interest
References
- Myers, N.; Mittermeier, R.A.; Mittermeier, C.G.; da Fonseca, G.A.B.; Kent, J. Biodiversity Hotspots for Conservation Priorities. Nature 2000, 403, 853–858. [Google Scholar] [CrossRef] [PubMed]
- Hawkins, F.; Safford, R.; Skerrett, A. Birds of Madagascar and the Indian Ocean Islands; Christopher Helm: London, UK, 2015. [Google Scholar]
- Reddy, S.; Driskell, A.; Rabosky, D.L.; Hackett, S.J.; Schulenberg, T.S. Diversification and the Adaptive Radiation of the Vangas of Madagascar. Proc. R. Soc. B Biol. Sci. 2012, 279, 2062–2071. [Google Scholar] [CrossRef] [PubMed]
- Jønsson, K.A.; Fabre, P.H.; Fritz, S.A.; Etienne, R.S.; Ricklefs, R.E.; Jørgensen, T.B.; Fjeldså, J.; Rahbek, C.; Ericson, G.P.; Woog, F.; et al. Ecological and Evolutionary Determinants for the Adaptive Radiation of the Madagascan Vangas. Proc. Natl. Acad. Sci. USA 2012, 109, 6620–6625. [Google Scholar] [CrossRef] [PubMed]
- Bristol, R.M.; Fabre, P.H.; Irestedt, M.; Jønsson, K.A.; Shah, N.J.; Tatayah, V.; Warren, B.H.; Groombridge, J.J. Molecular Phylogeny of the Indian Ocean Terpsiphone Paradise Flycatchers: Undetected Evolutionary Diversity Revealed amongst Island Populations. Mol. Phylogenet. Evol. 2013, 67, 336–347. [Google Scholar] [CrossRef]
- Dickinson, E.C.; Christidis, L. The Howard and Moore Complete Checklist of the Birds of the World, 3rd ed.; Princeton University Press: Princeton, NJ, USA, 2014. [Google Scholar]
- Pasquet, E.; Pons, J.M.; Fuchs, J.; Cruaud, C.; Bretagnolle, V. Evolutionary History and Biogeography of the Drongos (Dicruridae), a Tropical Old World Clade of Corvoid Passerines. Mol. Phylogenet. Evol. 2007, 45, 158–167. [Google Scholar] [CrossRef]
- Tateno, M.; Nakamura, M. Breeding Ecology of the Ashy Cuckoo-Shrike Coracinacinerea. Ornithol. Sci. 2009, 8, 147–150. [Google Scholar] [CrossRef]
- Fuchs, J.; Cruaud, C.; Couloux, A.; Pasquet, E. Complex Biogeographic History of the Cuckoo-Shrikes and Allies (Passeriformes: Campephagidae) Revealed by Mitochondrial and Nuclear Sequence Data. Mol. Phylogenet. Evol. 2007, 44, 138–153. [Google Scholar] [CrossRef]
- Eguchi, K.; Yamagishi, S.; Randrianasol, V. The Composition and Foraging Behaviour of Mixed-Species Flocks of Forest-Living Birds in Madagascar. IBIS 1993, 135, 91–96. [Google Scholar] [CrossRef]
- Savage, A.F.; Robert, V.; Goodman, S.M.; Raharimanga, V.; Raherilalao, M.J.; Andrianarimisa, A.; Dé, F.; Ariey, R.; Greiner, E.C. Blood Parasites in Birds from Madagascar. J. Wildl. Dis. 2009, 45, 907–920. [Google Scholar] [CrossRef][Green Version]
- Raharimanga, V.; Soula, F.; Mj, R.; Sm, G.; Randrianarivelojosia, M.; Raharimalala, L.; Jb, D.; Ariey, F.; Robert, V. Hémoparasites des Oiseaux Sauvages à Madagascar. Arch. Inst. Pasteur. De Madag. 2002, 68, 90–99. [Google Scholar]
- Greiner, E.C.; Putnam, M.S.; Goodman, S.M. Blood Parasites from Birds in the Re’serve Naturelle Integrale d’Andringitra, Madagascar. In Zoology 85; Fieldiana: Chicago, IL, USA, 1996; pp. 142–143. [Google Scholar]
- Barraclough, R.K.; Robert, V.; Peirce, M.A. New Species of Haematozoa from the Avian Families Campephagidae and Apodidae. Parasite 2008, 15, 105–110. [Google Scholar] [CrossRef] [PubMed][Green Version]
- Ivanova, K.; Zehtindjiev, P.; Mariaux, J.; Dimitrov, D.; Georgiev, B.B. Avian Haemosporidians from Rain Forests in Madagascar: Molecular and Morphological Data of the Genera Plasmodium, Haemoproteus and Leucocytozoon. Infect. Genet. Evol. 2018, 58, 115–124. [Google Scholar] [CrossRef] [PubMed]
- Musa, S.; Mackenstedt, U.; Woog, F.; Dinkel, A. Avian Malaria on Madagascar: Prevalence, Biodiversity and Specialization of Haemosporidian Parasites. Int. J. Parasitol. 2019, 49, 199–210. [Google Scholar] [CrossRef] [PubMed]
- Valkiunas, G. Avian Malaria Parasites and Other Haemosporidia; CRC Press: Boca Raton, FL, USA, 2005. [Google Scholar]
- Bensch, S.; Hellgren, O.; PÉrez-Tris, J. MalAvi: A Public Database of Malaria Parasites and Related Haemosporidians in Avian Hosts Based on Mitochondrial Cytochrome b Lineages. Mol. Ecol. Resour. 2009, 9, 1353–1358. [Google Scholar] [CrossRef]
- Zídková, L.; Cepicka, I.; Szabová, J.; Svobodová, M. Biodiversity of Avian Trypanosomes. Infect. Genet. Evol. 2012, 12, 102–112. [Google Scholar] [CrossRef]
- Valkiunas, G.; Iezhova, T.A.; Carlson, J.S.; Sehgal, R.N.M. Two New Trypanosoma Species from African Birds, with Notes on the Taxonomy of Avian Trypanosomes. J. Parasitol. 2011, 97, 924–930. [Google Scholar] [CrossRef]
- Šlapeta, J.; Morin-Adeline, V.; Thompson, P.; McDonell, D.; Shiels, M.; Gilchrist, K.; Votýpka, J.; Vogelnest, L. Intercontinental Distribution of a New Trypanosome Species from Australian Endemic Regent Honeyeater (Anthochaera Phrygia). Parasitology 2016, 143, 1012–1025. [Google Scholar] [CrossRef]
- Binkienė, R.; Chagas, C.R.F.; Bernotienė, R.; Valkiūnas, G. Molecular and Morphological Characterization of Three New Species of Avian Onchocercidae (Nematoda) with Emphasis on Circulating Microfilariae. Parasit Vectors 2021, 14, 1–19. [Google Scholar] [CrossRef]
- Sehgal, R.N.M.; Jones, H.I.; Smith, T.B. Molecular Evidence for Host Specificity of Parasitic Nematode Microfilariae in Some African Rainforest Birds. Mol. Ecol. 2005, 14, 3977–3988. [Google Scholar] [CrossRef]
- Yohannes, E.; Woog, F. A Multi-Isotope and Morphometric Analysis to Uncover Ecological Niche Divergence in Two Endemic Island Birds from Madagascar: The Dark and Common Newtonia (Vangidae). J. Ornithol. 2020, 161, 137–147. [Google Scholar] [CrossRef]
- Wink, M. Use of DNA Markers to Study Bird Migration. J. Ornithol. 2006, 147, 234–244. [Google Scholar] [CrossRef]
- Ciloglu, A.; Ellis, V.A.; Bernotienė, R.; Valkiūnas, G.; Bensch, S. A New One-Step Multiplex PCR Assay for Simultaneous Detection and Identification of Avian Haemosporidian Parasites. Parasitol. Res. 2019, 118, 191–201. [Google Scholar] [CrossRef] [PubMed]
- Hellgren, O.; Waldenstrom, J.; Bensch, S. A New PCR Assay for Simultaneous Studies of Leucocytozoon, Plasmodium, and Haemoproteus from Avian Blood. J. Parasitol. 2004, 90, 797–802. [Google Scholar] [CrossRef] [PubMed]
- Bensch, S.; Stjernman, M.; Hasselquist, D.; Ostman, O.; Hansson, B.; Westerdahl, H.; Pinheiro, R.T. Host Specificity in Avian Blood Parasites: A Study of Plasmodium and Haemoproteus Mitochondrial DNA Amplified from Birds. Proc. R. Soc. B Biol. Sci. 2000, 267, 1583–1589. [Google Scholar] [CrossRef] [PubMed]
- Nadler, S.A.; Hudspeth, D.S.S. Ribosomal DNA and Phylogeny of the Ascaridoidea (Nemata: Secernentea): Implications for Morphological Evolution and Classification. Mol. Phylogenet. Evol. 1998, 10, 221–236. [Google Scholar] [CrossRef] [PubMed]
- Casiraghi, M.; Anderson, T.J.C.; Bandi, C.; Bazzocchi, C.; Genchi, C. A Phylogenetic Analysis of Filarial Nematodes: Comparison with the Phylogeny of Wolbachia Endosymbionts. Parasitology 2001, 122, 93–103. [Google Scholar] [CrossRef]
- Benson, D.A.; Cavanaugh, M.; Clark, K.; Karsch-Mizrachi, I.; Lipman, D.J.; Ostell, J.; Sayers, E.W. GenBank. Nucleic Acids Res. 2013, 41, D36–D42. [Google Scholar] [CrossRef]
- Kumar, S.; Stecher, G.; Li, M.; Knyaz, C.; Tamura, K. MEGA X: Molecular Evolutionary Genetics Analysis across Computing Platforms. Mol. Biol. Evol. 2018, 35, 1547–1549. [Google Scholar] [CrossRef]
- Mafie, E.; Saito-Ito, A.; Kasai, M.; Hatta, M.; Rivera, P.T.; Ma, X.H.; Chen, E.R.; Sato, H.; Takada, N. Integrative Taxonomic Approach of Trypanosomes in the Blood of Rodents and Soricids in Asian Countries, with the Description of Three New Species. Parasitol Res. 2019, 118, 97–109. [Google Scholar] [CrossRef]
- Musa, S.; Mackenstedt, U.; Woog, F.; Dinkel, A. Untangling the Actual Infection Status: Detection of Avian Haemosporidian Parasites of Three Malagasy Bird Species Using Microscopy, Multiplex PCR, and Nested PCR Methods. Parasitol. Res. 2022, 121, 2817–2829. [Google Scholar] [CrossRef]
- Savage, A.F.; Greiner, E.C. Haemoproteids of the Avian Family Dicruridae (the Drongos). J. Parasitol. 2005, 91, 131–134. [Google Scholar] [CrossRef] [PubMed]
- Cornuault, J.; Bataillard, A.; Warren, B.H.; Lootvoet, A.; Mirleau, P.; Duval, T.; MilÚ, B.; ThÉbaud, C.; Heeb, P. The Role of Immigration and In-Situ Radiation in Explaining Blood Parasite Assemblages in an Island Bird Clade. Mol. Ecol. 2012, 21, 1438–1452. [Google Scholar] [CrossRef] [PubMed]
- Galen, S.C.; Nunes, R.; Sweet, P.R.; Perkins, S.L. Integrating Coalescent Species Delimitation with Analysis of Host Specificity Reveals Extensive Cryptic Diversity despite Minimal Mitochondrial Divergence in the Malaria Parasite Genus Leucocytozoon. BMC Evol. Biol. 2018, 18, 1–15. [Google Scholar] [CrossRef] [PubMed]
- Savage, A.F.; Ariey, F.; Greiner, E.C. Hematozoa of the Avian Family Vangidae (the Vangas). J. Parasitol. 2004, 90, 1475–1479. [Google Scholar] [CrossRef] [PubMed]
- Savage, A.F.; Ariey, F.; Greiner, E.C. A New Species of Plasmodium from Malagasy Vangas. J. Parasitol. 2005, 91, 926–930. [Google Scholar] [CrossRef]
- Sehgal, R.N.M.; Jones, H.I.; Smith, T.B. Host Specificity and Incidence of Trypanosoma in Some African Rainforest Birds: A Molecular Approach. Mol. Ecol. 2001, 10, 2319–2327. [Google Scholar] [CrossRef]
- Bennett, G.F.; Earle, R.A.; Squires-Parsons, D. Trypanosomes of Some Sub-Saharan Birds. Onderstepoort J. Vet. Res. 1994, 61, 263–271. [Google Scholar]
- Santolíková, A.; Brzoňová, J.; Čepička, I.; Svobodová, M. Avian Louse Flies and Their Trypanosomes: New Vectors, New Lineages and Host–Parasite Associations. Microorganisms 2022, 10, 584. [Google Scholar] [CrossRef]
- Svobodová, M.; Dolnik, O.V.; Čepička, I.; Rádrová, J. Biting Midges (Ceratopogonidae) as Vectors of Avian Trypanosomes. Parasit Vectors 2017, 10, 1–9. [Google Scholar] [CrossRef]
- Maia da Silva, F.; Marcili, A.; Ortiz, P.A.; Epiphanio, S.; Campaner, M.; Catão-Dias, J.L.; Shaw, J.J.; Camargo, E.P.; Teixeira, M.M.G. Phylogenetic, Morphological and Behavioural Analyses Support Host Switching of Trypanosoma (Herpetosoma) Lewisi from Domestic Rats to Primates. Infect. Genet. Evol. 2010, 10, 522–529. [Google Scholar] [CrossRef]
- Maraghi, S.; Wallbanks, K.R.; Molyneux, D.H. Oral Transmission of Trypanosomes of the Subgenus Herpetosoma from Small Mammals. Parasitol Res. 1995, 81, 693–695. [Google Scholar] [CrossRef] [PubMed]
- Apanius, V. Avian Trypanosomes as Models of Hemoflagellate Evolution. Parasitol. Today 1991, 7, 87–90. [Google Scholar] [CrossRef]
- Atkinson, C.T.; Thomas, N.J.; Hunter, D.B. (Eds.) Parasitic Diseases of Wild Birds; Wiley-Blackwell: New Delhi, India, 2008; ISBN 9780813820811. [Google Scholar]

| Haemosporida | Trypanosoma | microfilariae | |||||||||
| bird species | Nbs | N | Pmic | Pmol | lineages (n) | Pmic | Pmol | sequence (n) | Pmic | Pmol | sequence (n) |
| Campephagidae | |||||||||||
| Coracina cinerea | 3 | 4 | 25 | 75 | lFOUOMI07 (3) | 0 | 0 | - | 0 | 0 | - |
| Dicruridae | |||||||||||
| Dicrurus forficatus | 2 | 8 | 0 | 0 | - | 0 | 12.5 | T. avium CORVOID2 | 0 | 0 | - |
| Monarchidae | |||||||||||
| Terpsiphone mutata | 21 | 40 | 4.8 | 12.5 | pCOPALB03 (2), lCINSOV02, lTERMUT01, one unidentified Leucocytozoon double infection | 0 | 27.5 | T. anguiformisCORVOID03 (2), T. avium CORVOID1, T. avium CORVOID3, T. avium (KT728402) (5), T. avium CORVOID4 (2) | 0 | 2.5 | Aproctella alessandroi (1) |
| Vangidae | |||||||||||
| Calicalicus madagascariensis | 5 | 12 | 0 | 58.3 | pBERZOS01, lANLAT11, lCALMAD01 (2), lCALMAD02, lCALMAD03, lCALMAD04, lHYPMA02 | 0 | 25 | T. avium (KT728402) (2), Trypanosoma sp. CORVOID01 | 0 | 0 | - |
| Cyanolanius madagascarinus | 0 | 4 | - | 50 | pBERZOS01, pFOUMAD03, hCYAMAD01, lCYAMAD02 | - | 25 | double infection | - | 0 | - |
| Hypositta corallirostris | 0 | 1 | - | 100 | Leucocytozoon sp. double infection | - | 0 | T. avium CORVOID4 | - | 0 | - |
| Leptopterus chabert | 2 | 2 | 100 | 100 | hLEPCHA01 (2), lLEPCHA02, lLEPCHA03 | 50 | 0 | 0 | 0 | 0 | - |
| Mystacornis crossleyi | 0 | 6 | - | 16.7 | Haemoproteus micronuclearis RBQ11 | - | 0 | 0 | - | 50 | Onchocercidaesp. CROSSBAB (1), Onchocercidae sp. CROSSBAB2 (2) |
| Newtonia amphichroa | 12 | 26 | 8.3 | 76.9 | pNEWAM05 (2), pNEWAM01 (4), pNEWAM07 (3), hNEWAM04 (6), lFOMAD01, lNEWAM08 | 0 | 7.7 | Trypanosomasp. CORVOID02, T. avium (KT728401) | 8.3 | 7.7 | Onchocercidaesp. DANEW (2) |
| Newtonia brunneicauda | 5 | 12 | 100 | 100 | pNEWAM06, hNEWBR01, hNEWBR02, hNEWBR03, hNEWBR04, hNEWBR05 (4), hNEWBR07, lNEWAM03 (5), lNEWBR06, lZOMAD01 | 0 | 33.3 | T. aviumCORVOID2, T. avium CORVOID1 (2), T. avium (KT728402) | 0 | 0 | - |
| Pseudobias wardi | 1 | 4 | 100 | 100 | Plasmodium relictum GRW04, hPSEWAR01 (2), hPSEWAR03, lPSEWAR02 | 0 | 50 | T. avium (KT728401), T. anguiformis CORVOID03 | 0 | 0 | - |
| Tylas eduardi | 2 | 9 | 50 | 77.8 | Plasmodium relictum GRW04 (3), hTYLEDU01, hTYLEDU04, lCALMAD01 (2), lTYLEDU02 (2), lTYLEDU03 | 0 | 22.2 | T. lewisi (GU252209), T. avium (KT728402) | 0 | 11.1 | Splendidofilaria bartlettiTYLAS (1) |
| Vanga curvirostris | 2 | 2 | 100 | 100 | pNEWAM07, hVANCUR01, lVANCUR02 (2) | 50 | 50 | T. avium CORVOID4 | 0 | 0 | |
| Xenopirostris polleni | 1 | 1 | 0 | 100 | pNEWAM07, lXENPOL01 | 0 | 0 | 0 | 0 | 0 | |
| total Vangidae | 30 | 79 | 43.3 | 79.7 | 6.6 | 20.3 | 33.3 | 7.6 | |||
| total for the four families | 56 | 131 | 26.8 | 54.2 | 3.6 | 21.4 | 1.8 | 5.3 | |||
| genus | lineage name | bird species | N | porcentage (%) | other hosts | site |
| Plasmodium | BERZOS01 | Calicalicus madagascariensis | 1 | 33.3 | Xanthomixis zosterops, Bernieria madagascariensis | Madagascar |
| Cyanolanius madagascarinus | 1 | 50 | ||||
| COPALB03 | Terpsiphone mutata | 2 | 100 | Copsychus albospecularis | Madagascar | |
| FOUMAD03 | Cyanolanius madagascarinus | 1 | 50 | 11 species | Madagascar | |
| P. relictum (GRW04) | Tylas eduardi | 3 | 50 | 91 species | worldwide | |
| Pseudobias wardi | 1 | 50 | ||||
| NEWAM05 | Newtonia amphicroa | 2 | 11.1 | Bernieria madagascariensis, Foudia omissa | Madagascar | |
| NEWAM01 | Newtonia amphicroa | 4 | 22.2 | - | ||
| Newtonia brunneicauda | 1 | 16.6 | ||||
| NEWAM07 | Newtonia amphicroa | 3 | 16.6 | - | ||
| Vanga curvirostris | 1 | 100 | ||||
| Xenopirostris polleni | 1 | 100 | ||||
| Haemoproteus | CYAMAD01 | Cyanolanius madagascarinus | 1 | 50 | - | |
| LEPCHA01 | Leptopterus chabert | 2 | 100 | - | ||
| NEWAM04 | Newtonia amphicroa | 6 | 66.6 | - | ||
| NEWBR01-03,04 | Newtonia brunneicauda | 1 | 8.3 | - | ||
| NEWBR05 | Newtonia brunneicauda | 4 | 33.3 | - | ||
| NEWBR07 | Newtonia brunneicauda | 1 | 8.3 | - | ||
| PSEWAR01 | Pseudobias wardi | 2 | 40.0 | - | ||
| PSEWAR03 | Pseudobias wardi | 1 | 20 | - | ||
| H. micronuclearis (RBQ11) | Mystacornis crossleyi | 1 | 100 | Quelea quelea, Q. erythrops, Ploceus melanocephalus, Foudia omissa, F. madagascariensis (Ploceidae) | sub-Saharan Africa | |
| TYLEDU01 | Tylas eduardi | 2 | 66.6 | - | ||
| TYLEDU04 | Tylas eduardi | 1 | 33.3 | - | ||
| VANCUR01 | Vanga curvirostris | 1 | 100 | - | ||
| Leucocytozoon | ANLAT11 | Calicalicus madagascariensis | 1 | 9 | Andropadus latirostris | Ghana |
| CALMAD01 | Tylas eduardi | 2 | 22.2 | - | ||
| Calicalicus madagascariensis | 2 | 18.1 | ||||
| CALMAD02-04 | Calicalicus madagascariensis | 1 | 9 | - | ||
| CINSOV02 | Terpsiphone mutata | 1 | 25 | Cinnyris sovimanga | Madagascar | |
| CYAMAD02 | Cyanolanius madagascarinus | 1 | 100 | - | ||
| FOMAD01 | Newtonia amphicroa | 1 | 33.3 | Foudia madagascariensis, F. omissa, F. eminentissima, Hypsipetes madagascariensis | Comoros, Mayotte | |
| FOUOMI07 | Coracina cinerea | 3 | 100 | - | ||
| HYPMA02 | Calicalicus madagascariensis | 1 | 9 | Foudia omissa, F. madagascariensis, Hypsipetes madagascariensis, Neodrepanis coruscans, Philepitta castanea | Madagascar | |
| LEPCHA02-03 | Leptopterus chabert | 1 | 25 | - | ||
| NEWAM03 | Newtonia brunneicauda | 5 | 71.4 | Foudia omissa, N. amphicroa | Madagascar | |
| NEWAM08 | Newtonia amphicroa | 1 | 33.3 | - | ||
| NEWBR06 | Newtonia brunneicauda | 1 | 14.3 | - | ||
| PSEWAR02 | Pseudobias wardi | 1 | 33.3 | - | ||
| TERMUT01 | Terpsiphone mutata | 1 | 25 | - | ||
| TYLEDU02 | Tylas eduardi | 2 | 22.2 | - | ||
| TYLEDU03 | Tylas eduardi | 1 | 11.1 | - | ||
| VANCUR02 | Vanga curvirostris | 2 | 100 | - | ||
| XENPOL01 | Xenopirostris polleni | 1 | 100 | - | ||
| ZOMAD01 | Newtonia brunneicauda | 1 | 14.3 | Zosterops maderaspatanus | Madagascar |
Publisher’s Note: MDPI stays neutral with regard to jurisdictional claims in published maps and institutional affiliations. |
© 2022 by the authors. Licensee MDPI, Basel, Switzerland. This article is an open access article distributed under the terms and conditions of the Creative Commons Attribution (CC BY) license (https://creativecommons.org/licenses/by/4.0/).
Share and Cite
Magaña Vázquez, R.; Woog, F.; Dinkel, A.; Mackenstedt, U.; Musa, S. Blood Parasites of Vangas and Other Corvoidea on Madagascar. Diversity 2022, 14, 888. https://doi.org/10.3390/d14100888
Magaña Vázquez R, Woog F, Dinkel A, Mackenstedt U, Musa S. Blood Parasites of Vangas and Other Corvoidea on Madagascar. Diversity. 2022; 14(10):888. https://doi.org/10.3390/d14100888
Chicago/Turabian StyleMagaña Vázquez, Regina, Friederike Woog, Anke Dinkel, Ute Mackenstedt, and Sandrine Musa. 2022. "Blood Parasites of Vangas and Other Corvoidea on Madagascar" Diversity 14, no. 10: 888. https://doi.org/10.3390/d14100888
APA StyleMagaña Vázquez, R., Woog, F., Dinkel, A., Mackenstedt, U., & Musa, S. (2022). Blood Parasites of Vangas and Other Corvoidea on Madagascar. Diversity, 14(10), 888. https://doi.org/10.3390/d14100888

